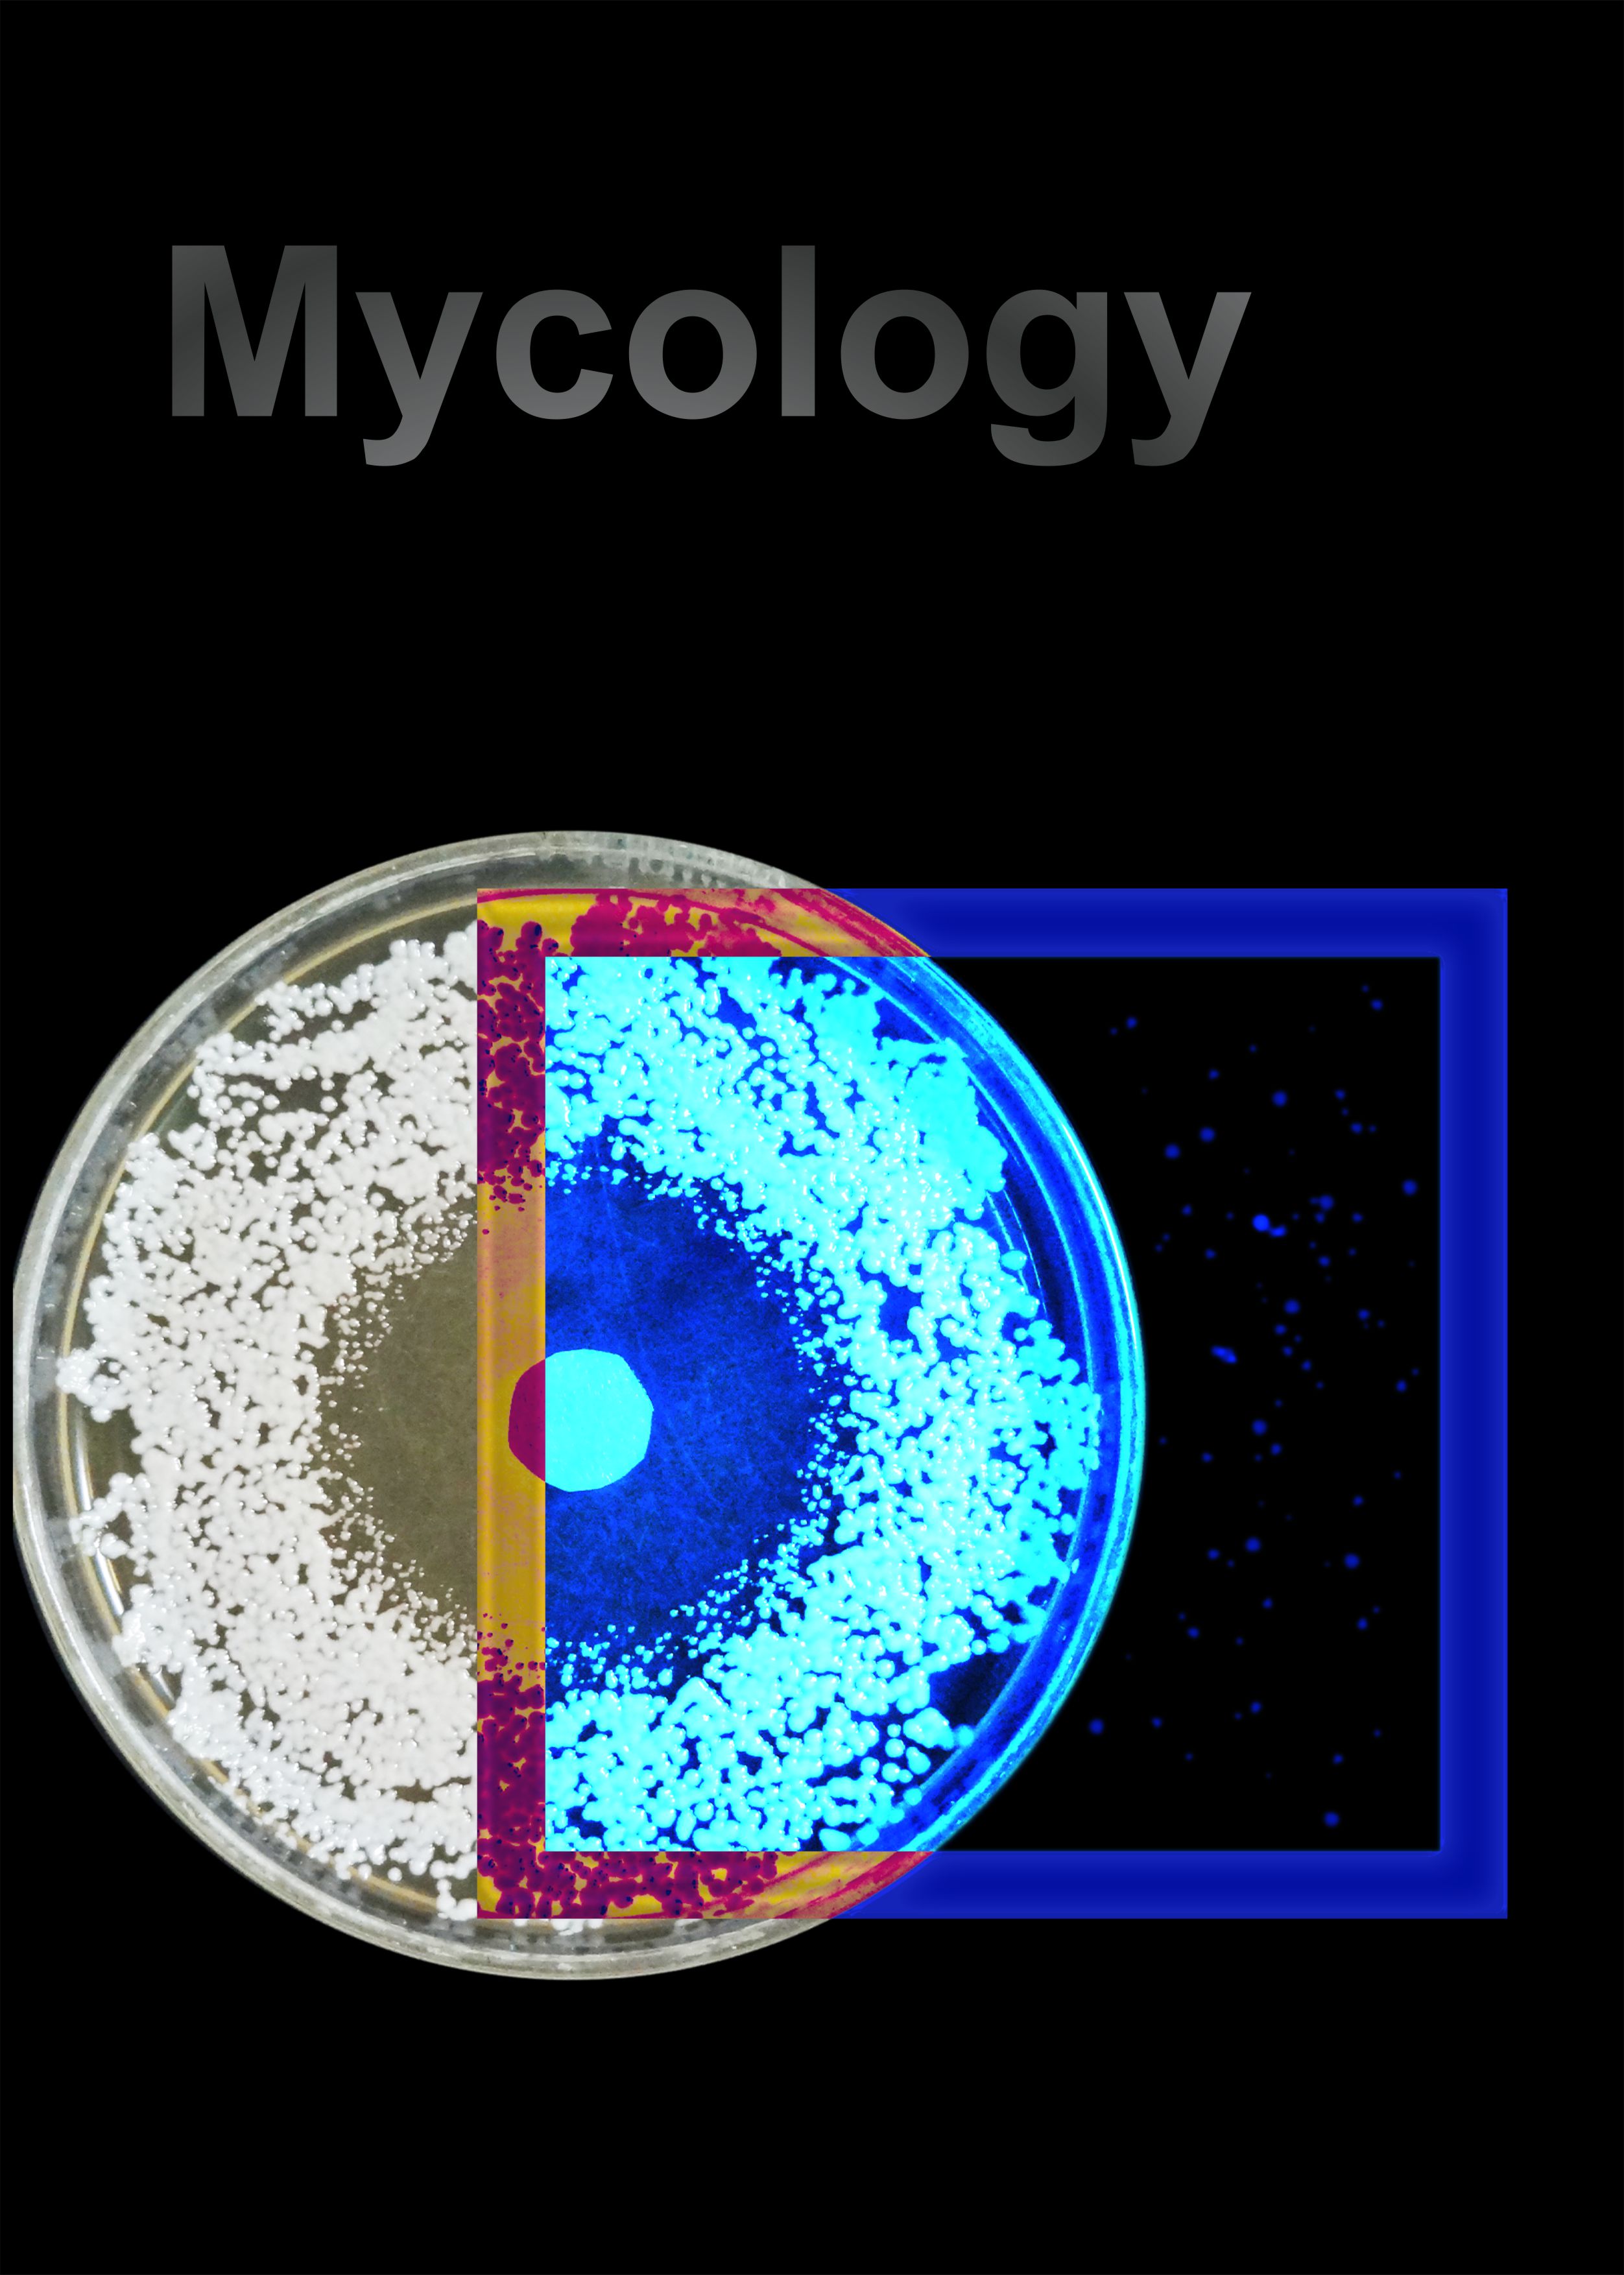

A compilation of in-vivo and in-vitro experimental research papers published in various journals, dating back to 1980, on the efficacy of homoeopathic medicines in plant and animal viruses as well as fungal infections.
Book release
Released on 9th April 2022 by Shri Sarbananda Sonowal, Hon’ble Cabinet Minister of Ayush, Shipping and Waterways in Government of India in a scientific convention on the occasion of World Homoeopathy Day (WHD-2022) at Bharat Ratna C. Subramaniam Auditorium, New Delhi.
Present on the dais:
- Dr. Munjpara Mahendrabhai, Honb’le Minster of State (MoS), Ministry of Ayush and Ministry of Women & Child Development
- Sri Manoj Rajoria, Member of Parliament in Lok Sabha
- Sri Vaidya Rajesh Kotecha, Secretary, Ministry of Ayush
- Sri D. Senthil Pandiyan (IAS), Joint Secretary, Ministry of Ayush
- Sri Pramod Kumar Pathak, Special Secretary, Ayush Education Policy
- Dr. Sangeeta A. Duggal, Advisor (Homoeopathy), Ministry of Ayush
- Dr. Anil Khurana, Chairman, National Homoeopathic Commission
- Dr. Subhash Kaushik, Director General, Central Council for Research in Homoeopathy (CCRH)
- Dr. Subhas Singh, Director, National Institute of Homoeopathy (NIH)
- Padamshree Dr. V. K. Gupta
Need for the book
Our experimental research papers are scattered across journals over period of almost 27 years and it is difficult to access them in one place.
Scarcity of practical demonstration of in-vivo and in-vitro research methodology.
A good reference for researchers in homoeopathy .
Salient features
Objective, irrevocable in-vivo and in-vitro experiments to prove that potentized homoeopathic medicines are biologically active and cannot be antidote by crude substances.
Not a theoretical book but actual experimental research including methodology.
An effective tool in convincing the non-believers of homoeopathy.
Historical research papers dating back to 1980 enhanced with fortified coloured images and graphs to make them more interesting.
It will be of immense help as reference book to research scholars in their pursuit of guidance for experimental research methodology and learning research skill.
Need for experimental research
Time and again, the credibility of Homoeopathy has been questioned and it has been rendered ‘Unscientific’ by labelling it as ‘Placebo’, ‘Psychotherapy’, ‘Aquatherapy’ and so on, as if it’s no better than voodoo. The reason is scarcity of evidence-based experimental and clinical research. Thus, an experimental research model was needed through which action of homoeopathic drugs could be demonstrated objectively.
| Problem: Homoeopathy is | Solution |
|---|---|
| Placebo Aqua therapy Inhibited by food items / crude substances | in-vivo and in-vitro experiments for objective results |
| Psychotherapy | test homoeopathic drugs on plants and animals |
About the book
ISBN: 978-81-952355-3-7
This book ‘Experimental Homoeopathy’ is broadly divided into two sections namely Virology and Mycology. It contains 16 experimental research papers- 6 on anti-viral effect of homoeopathic drugs against plant and animal viruses (including 1 review paper) and 7 on anti-fungal efficacy of these drugs against human pathogenic fungi. Additional 3 papers have been included on the evaluation of inhibitory effect of forbidden food items, beverages and certain allopathic drugs, if any, on the efficacy of homoeopathic medicines in in-vitro models.

Virology section begins with experimental work eliciting the inhibitory effect of homoeopathic medicines on Tobacco Mosaic Virus (TMV) conducted in virology laboratory of National Botanical Research Institute (NBRI), Lucknow. The key attraction in Virology section is the experimental work on animal model in the Department of Virology in Central Drug Research Institute (CDRI), Lucknow, evaluating anti-viral property of homoeopathic drugs against Chicken Embryo Virus (CEV) and Simliki Forest Virus (SFV) causing viral encephalitis disease or death of mice. It also includes a review paper to abstract the information from available literature work about safe and economical prevention of different viral and fungal diseases of plants and animals.
The opening paper of Mycology section is on the effect of homoeopathic drugs on the growth of Alternaria tenuis Auct. and Curvularia lunata (Wakker) Boedijn, the common leaf spot pathogens of ornamental and cultivated plants. It is followed by various in-vitro researches conducted in collaboration with the Microbiologist of National Research Laboratory for Conservation (NRLC), Lucknow, Scientist of CDRI and Medical Mycologist in Medical Mycology lab. of Gaurang Clinic and Centre for Homoeopathic Research, GCCHR on the effect of homoeopathic drugs against various species of Candida, Trichophyton, Aspergillus, Microsporum and Curvularia isolated from human patients.

This is followed by 3 exclusive experiments to elicit whether various forbidden food stuffs (garlic, onion, cardamom, clove, caraway, ginger, fenugreek, black pepper, asafoetida, red chilli, green chilli, turmeric, lemon and camphor), beverages (tea, coffee), some other items (tobacco and bhang) and allopathic medicines inhibit the antifungal activity of homoeopathic medicines.
Features
Few papers are historical and date back to 1980 when technological resources were scarce. For this reason, the resolution of many images has been drastically enhanced and fortified with colours for better appreciation of lesions/organisms and with coloured graphical illustrations, which were not part of the original published papers. The original images have, however, been included to maintain the integrity.



Author

Dr. Girish Gupta, is a senior homoeopathic practitioner who committed his life to upliftment of homoeopathy through scientific research from a very young age. Throughout his professional career of 38 years he has conducted numerous researches, be it experimental or clinical, with unshaken dedication in various fields of specialty and published them in reputed international and national journals.







